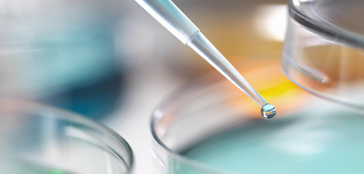

浙江环新氟材料有限公司是专注于氟硅氧烷材料,特殊氟化学品和低GWP产品的中国主要生产制造机构。公司建立在强有力的专有技术,市场,专用氟材料生产资产与独创能力结合基础上,不断创新发展。制造供应高性能,高品质的专用氟材料产品,是我们对国内外客户的承诺。

制造专用氟化工产品二十多年的技术力量,严格的产品质量控制,
使公司成为满足市场与客户对专用氟化工材料产品成长需要的可靠资源供应商。
地 址: 浙江省衢州市念化路31号1幢1号
电 话: 0579-87271588 / 87271783
手 机: 13375895268
邮 件: huanxin@huanxinfluoro.com
